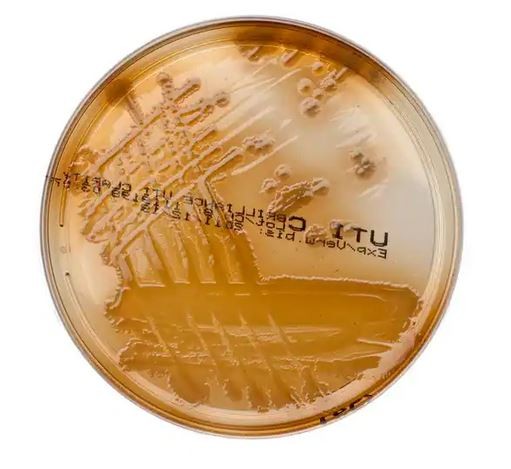
uti.jpg

Cookie-Einstellungen
Diese Website benutzt Cookies, die für den technischen Betrieb der Website erforderlich sind und stets gesetzt werden. Andere Cookies, die den Komfort bei Benutzung dieser Website erhöhen, der Direktwerbung dienen oder die Interaktion mit anderen Websites und sozialen Netzwerken vereinfachen sollen, werden nur mit Ihrer Zustimmung gesetzt.
Konfiguration
Technisch erforderlich
Diese Cookies sind für die Grundfunktionen des Shops notwendig.
"Alle Cookies ablehnen" Cookie
"Alle Cookies annehmen" Cookie
Ausgewählter Shop
CSRF-Token
Cookie-Einstellungen
Individuelle Preise
Kunden-Wiedererkennung
Kundenspezifisches Caching
Session
Währungswechsel
Komfortfunktionen
Diese Cookies werden genutzt um das Einkaufserlebnis noch ansprechender zu gestalten, beispielsweise für die Wiedererkennung des Besuchers.
Merkzettel
Statistik & Tracking
Endgeräteerkennung
Partnerprogramm
Brilliance UTI CLARITY
Mengeneinheit: 20 Stück
Art.Nr.: PO5159A
Preise durch Login freischalten
- Artikel-Nr.: PO5159A
- Hersteller-Nr.: PO5159A
Brilliance™ UTI Clarity™ Präsumtive Identifizierung von... mehr
Brilliance™ UTI Clarity™
Präsumtive Identifizierung von den häufigsten Erregern einer Harnwegsinfektion
Die Medien Brilliance™ UTI und UTI Clarity™ Nährböden dienen der Differenzierung und präsumtiven Identifizierung von Keimen bei Harnwegsinfektionen (Urinary Tract Infection, UTI).
Verfügbare Downloads:








